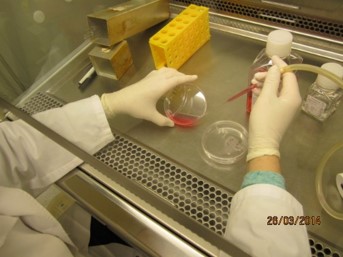
© MedUni Wien/Zentrum für Hirnforschung

Welcome to the homepage of the PhD Program Neuroscience

The success of our program is driven by the outstanding, engaged faculty members participating with their research projects but also devoted to the education of the PhD-students (as for example with the joint lecture Basics of Neuroscience II). We aim to provide a broad neuroscience education on top of the specific research project of the thesis. This is implemented through the lab rotation, the rotation of the Journal Club (each semester in another department with a different neuroscientific focus) or joint retreats with broad discussion of all research projects to see the own project from very different perspectives.
The other driving force are the outstanding PhD students, organising regular events like the semester starting party at the beginning of each semester allowing newly enrolled but also advanced students to ask questions, getting an update on program developments, and offer for the upcoming semester by the program coordinator – and then, getting to know each other better by spending an evening and the night :-) with fun and neuroscience at the Center for Brain Research.
Univ.-Prof. Dr. Johannes Berger
Program Coordinator (contact)